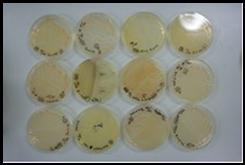

海産無脊椎動物と共生する細菌群の特定
本研究室では海産無脊椎動物のうち、巻貝や二枚貝と共生する細菌群の特定を行っている。とくにアワビから見つかってきた新規のイプシロンプロテオバクテリアは、その現存量がエラなどの特定の器官に多いこと、かつその種類が多様であることを明らかにしている。今後はこれらの新規のイプシロンプロテオバクテリアの特異検出法の開発と宿主内での動態解析を行う。また、これらイプシロンプロテオバクテリアの分類学的検討および生態学的検討(宿主との栄養共生関係の解明)を行う。

次世代シーケンスによるアワビのエラの細菌相解析(黄色で示した部分)
そのほとんどが新規のイプシロンプロテオバクテリアである(PeerJ. Mizutani et al., 2020)

これらの新規のイプシロンプロテオバクテリアは既存の生物との遺伝学的な相同性が低く、
新属であると考えられる

これらの新規のイプシロンプロテオバクテリアはエラに特異的に存在し、マイクロコロニーを形成することが明らかになった。(PeerJ. Mizutani et al., 2020)

イプシロンプロテオバクテリアの新種、Arcobacter haliotis strain MA5
(Int. J. Syst. Evol. Microbiol. Tanaka et al., 2017)
・海産無脊椎動物に付随する新規イプシロンプロテオバクテリア群の網羅解析
・未培養イプシロンプロテオバクテリアのゲノムおよび機能解析
・海産無脊椎動物由来アルコバクター属細菌群の分離および記載

水産プロバイオティクスの有効性の実証
本研究室では水産養殖におけるプロバイオティクス技術の開発をおこなっている。モデル生物としてアワビを用いて病原細菌に対して増殖阻害効果を持つ乳酸菌の分離に成功している。今後はこれら乳酸菌の特異検出法の開発と宿主内での動態解析を行う。

Alexa488標識プローブを用いたプロバイオティクス菌の特異検出(FISH)
(Fish sci. Tanaka et al., 2016)


アワビ消化管超薄切片を用いたプロバイオティクス菌の付着部位特定
(Fish sci. Tanaka et al., 2016)

1年間のアワビ消化管内のアルギン酸分解細菌相の変化
(Aquaculture res. Tanaka et al.,2015)

これまでに分離したアワビ消化管内細菌群の16S rRNA遺伝子の多様
(Aquaculture res. Tanaka et al.,2015)
・乳酸菌を用いたアワビのプロバイオティクス養殖技術の開発
・アワビ消化管内細菌群の動態解析およびモニタリング
・アワビ消化管内細菌の特異検出法の開発
・アワビ消化管内細菌のメタボローム解析
・アワビ消化管内細菌群のメタゲノム解析
海洋細菌を用いた海藻バイオリファイナリー
未利用水産資源のバイオリファイナリー(分解、発酵)に関する研究を行っている。現在は2つのプロジェクトのもとで褐藻(クロメ)、および緑藻(アオサ)を用いた糖化および発酵について研究しているが、新種の海藻分解細菌などのゲノム解析および海藻分解関連遺伝子の特定などを行っている。今後は褐藻からピルビン酸やコハク酸などの化成品基幹物質の生産を目指す。また緑藻に含まれる硫酸多糖類(ウルバン)の単糖化およびその生理機能を把握する。

褐藻類からのバイオリファイナリー。本研究室ではアルギン酸から得られる単糖(DEH)について、その化成品としての利用法や、微生物変換について研究している。

アルギン酸から得られる単糖(DEH)については研究目的でのMTA(有償提供)が可能です。お気軽にご相談ください。

褐藻分解細菌によるコンブの分解

褐藻を強力に分解する新種の細菌Formosa haliotis
(Int. J. Syst. Evol. Microbiol. Tanaka et al., 2015)


褐藻構成多糖から乳酸を生成する海洋細菌のスクリーニング




緑藻に含まれる硫酸多糖類(ウルバン)を低分子化する細菌のライブラリー及び
スクリーニング法の開発

新規ビブリオ属細菌のウルバン分解関連遺伝子(PUL)の解明
(Microbiol. Resour. Ann. Tanaka et al., 2024)


海洋細菌Formosa haliotisを用いた褐藻多糖発酵代謝産物解析(コハク酸の生産)


合成褐藻成分培地を用いた褐藻摂餌性魚類消化管内細菌の分離

勢水丸での海底泥サンプルの採取

本研究室に保管する約1000株の海洋細菌ライブラリーについては研究目的でのMTA(有償提供)が可能です。培養上清のみの提供も可能です。生理活性スクリーニング等にお使いください。
・海藻分解細菌の分離およびライブラリの作製
・各種海洋細菌の発酵代謝産物解析
・海洋細菌による海藻分解機構の解明